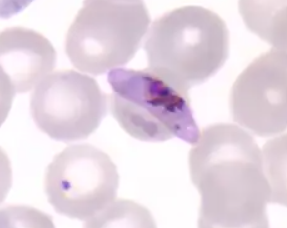
<p>Identify</p>
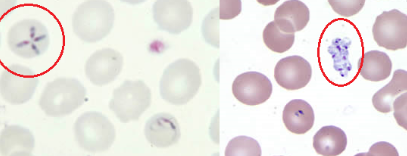
<p>The following organisms were seen on peripheral blood smears from a patient with recent travel to Connecticut. What is it?</p>

1/14
Looks like no tags are added yet.
Name | Mastery | Learn | Test | Matching | Spaced | Call with Kai |
|---|
No analytics yet
Send a link to your students to track their progress
Identify
Plasmodium faciparum
Which of the following are classified as Coccidian protozoans?
-Cryptosporidium species
-Toxoplasma gondii
-Sarcocystic species
What procedures is PVA ideal for?
-Permanently stained smears
The following organisms were seen on peripheral blood smears from a patient with recent travel to Connecticut. What is it?
Babesia species
What stain should be used for Coccidian protozoans due to trichomes’ poor staining performance with these organisms?
Modified acid fast
What vector is required for Plasmodium species?
Anopheles mosquitos

Identify organism & stage of development
Plasmodium vivax; schizont
Schuffner’s dot seen in:
-Plasmodium vivax
-Plasmodium ovale
Will ALL parasites be found on top of the supernatant in zinc sulfate flotation?
No, heavy ova like Ascaris will be found at the bottom of the tube instead.
For humans, what is the infective form of Plasmodium species?
Sporozoites
Humans are the definitive hosts for Plasmodium species.
False
Which Plasmodium species invade RBCs of all ages?
Plasmodium knowlesi
-Plasmodium falciparum
Which Plasmodium species can cause relapse due to dormant forms called hypnozoites in the liver?
-Plasmodium ovale
-Plasmodium vivax
Which stage of sporozoan development occurs in humans and what is the end product of this stage?
Schizogony; merozoites
What protozoan stage of development are you more likely to find in a formed stool specimen?
Cysts